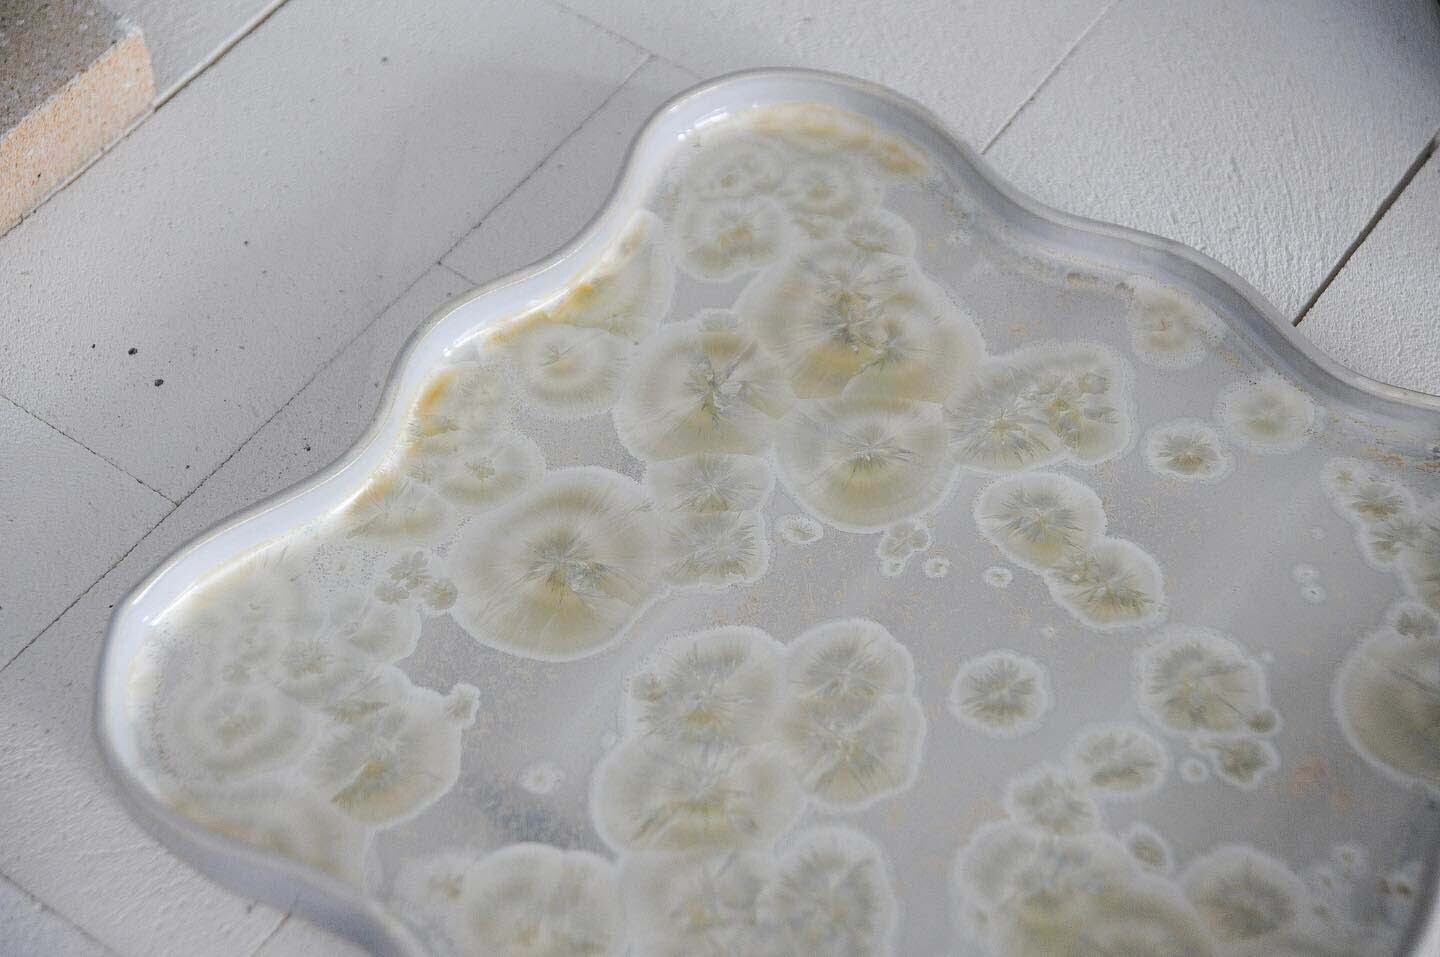
器息樂無事民藝陶器展

器息| 樂無事民藝陶器
展期 1/28 — 2/26
這次創作的3個關鍵字
有花的生活
協作
自己的冒險旅程
展覽⎡器息⎦融合各種陶瓷技法及釉彩變化
將當下的情感流動、直覺與片刻光影變換
轉譯在器物上。
樂無事,團隊成員有佳慧、昱升和暮暮,
以製作料理食器和花器為主,
因為喜歡料理、喜歡花藝,
對於生活有許多美好的想像,
希望有不一樣的餐桌風景。
如有喜歡的作品,
歡迎於聯絡我們填寫表單,
或透過LINE(ID: @183baclb)詢問。
器息| 樂無事民藝陶器
展期 1/28 — 2/26
這次創作的3個關鍵字
有花的生活
協作
自己的冒險旅程
展覽⎡器息⎦融合各種陶瓷技法及釉彩變化
將當下的情感流動、直覺與片刻光影變換
轉譯在器物上。
樂無事,團隊成員有佳慧、昱升和暮暮,
以製作料理食器和花器為主,
因為喜歡料理、喜歡花藝,
對於生活有許多美好的想像,
希望有不一樣的餐桌風景。
如有喜歡的作品,
歡迎於聯絡我們填寫表單,
或透過LINE(ID: @183baclb)詢問。